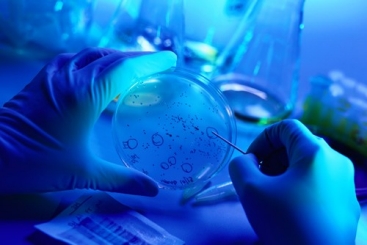

|
GFÆa∆∑ë™”√ –àˆ
 |
 |
Cooling / F & B÷∆¿‰∫Õ¿‰Ös
GFπе¿œµΩy(t®Øng)µƒ√˜¥_“‚àD «≥…ûÈ胃Б¥ π”√∫Õ≠h(hu®¢n)æ≥”∞Ìë∑Ω√ÊÉû(y®≠u)ªØ÷∆¿‰∫Õ¿‰Ös‘Olj≥´◊hµƒ“ª≤ø∑÷°£’˚ÇÄ÷∆¿‰‘Oljµƒþ\–––߬ »°õQ”⁄ôC∆˜µƒCOP£®–‘ƒÐœµîµ£©°¢∂˛¥Œπе¿œµΩy(t®Øng)µƒ–߬ ∫Õø’ö‚¿‰Ös∆˜µƒÇ˜ü·ÀŸ¬ °£“Ú¥À£¨∂˛¥Œπе¿œµΩy(t®Øng)嶒˚ÇÄÎäèSµƒ–߬ ∆÷¯÷¡ÍP÷ÿ“™µƒ◊˜”√°£GFµƒCOOL-FIT «“ªÇÄÓAΩ^æⵃÕÍ’˚ÀСœπе¿œµΩy(t®Øng)£¨å£ÈT‘O”ã”√”⁄Éû(y®≠u)ªØ∂˛¥Œπе¿œµΩy(t®Øng)µƒ–߬ °¢∞≤—b≥…±æ∫Õ π”√â€√¸°£
More Information |
Chemical Processing
ªØåWþ^≥Ã
GFπе¿œµΩy(t®Øng)‘⁄‘S∂ýªØåWþ^≥Ã÷–∂º «‘⁄ƒª∫Û≤Ÿ◊˜µƒ°£ªØπ§èS∫ÕªØπ§ðîÀÕµƒê∫¡”≠h(hu®¢n)æ≥å¶πе¿œµΩy(t®Øng)µƒ∞≤»´°¢∏þ–ß∫ÕæS◊o÷≥ˆ¡À∏¸∏þµƒ“™«Û°£”…”⁄Œ“ÇÉîµ ÆƒÍµƒΩõÚû∫ÕèV∑∫µƒå£òI(y®®)÷™◊R£¨Œ“ÇɃÐâÚ¥_±£Œ“ÇɵƒÆa∆∑∫Õ÷Ðá˙µÿÖ^(q®±)µƒ»À√ÒµƒŸ|¡ø∫Õ∞≤»´°£50∂ýƒÍÅÌ£¨π§òI(y®®)ΩÁ“ª÷±œý–≈≤£¡ß¿wæSπе¿œµΩy(t®Øng)µƒü·ÀЖ‘â∫¡¶πе¿œµΩy(t®Øng)þm”√”⁄èƒπ§ÀΈÖs”√ÀƵΩþ\ðÎU“∫Ûwµƒ∏˜∑Nπ§òI(y®®)ë™”√°£Œ“ÇÉÀ˘◊C√˜µƒÀСœπе¿œµΩy(t®Øng)÷π©¡À∏ØŒg∑¿◊o£¨…ı÷¡‘⁄ªØåWπ§òI(y®®)µ»æþ”–ÃÙë(zh®§n)–‘µƒπ§òI(y®®)≤øÈT°£
More Information |
 |
 |
Data Center
îµì˛÷––ƒ
ÎS÷¯îµì˛÷––ƒ≈¨¡¶≥…ûÈ∏¸∏þ–ßµƒƒÐ‘¥”√ëÙ£¨À¸ÇÉ’˝ÞDœÚ∏þ–ßµƒ“∫Ûw¿‰Ös“‘÷∏þœµΩy(t®Øng)µƒ–߬ °£GFπе¿œµΩy(t®Øng)ûÈ∏þ–ßîµì˛÷––ƒ¿‰Ösµƒ–¬–Ë«ÛÀ˘–˵ƒÍPÊI»ŒÑ’¿‰Ös÷π©¡Àπе¿œµΩy(t®Øng)°£GFπе¿œµΩy(t®Øng)÷π©√‚æS◊oÀСœΩ‚õQ∑Ω∞∏°¢àˆÕ‚ƒ£âKªØ÷∆‘Ï“‘åç¨F∏¸øϵƒΩ®‘Ï°¢üo–ËÑ”ª◊˜òI(y®®)µƒøÏÀŸ∞≤—b°¢∏þþ_70%µƒ÷ÿ¡øúpðp°¢∏¸∏þ–ßµƒπе¿œµΩy(t®Øng)°¢Ô@÷¯µƒÑ⁄Ñ”¡¶≥…±æπù(ji®¶)ºs£¨“‘º∞∞¸¿®œµΩy(t®Øng)åè≤È°¢«ÀâK∫Õƒ£âKªØ‘O”ã‘⁄É»µƒπ§≥Ã∑˛Ñ’°£
More Information |
Energy
ƒÐ‘¥
‘⁄ø…≥÷¿m(x®¥)–‘µƒ»’“Ê‘ˆè䵃“‚¡x…œ£¨…Óøõƒ◊ɪؒ˝È_ º∏ƒ◊ɃБ¥µƒ…˙Æa°¢ðîÀÕ∫Õ π”√∑Ω Ω°£Œ“ÇÉ‘⁄GFπе¿œµΩy(t®Øng)÷π©÷«ƒÐÀСœΩ‚õQ∑Ω∞∏£¨≥…π¶µÿπпÌ∏þ∂»å£òI(y®®)ªØµƒÀÆ∫ÕªØåWë™”√‘⁄ΩÒÃÏ∫Õ√˜ÃϵƒƒÐ‘¥…˙Æa°£üo’ìƒ˙ «å¶Ç˜Ωy(t®Øng)ÎäèS°¢ø…‘Ÿ…˙ƒÐ‘¥þÄ «È_Ñì(chu®§ng)–‘µƒæG…´Ω‚õQ∑Ω∞∏∏–≈d»§£¨Œ“ÇÉ∂ºø…“‘¿˚”√20∂ý∑N≤ªÕ¨≤ƒ¡œµƒ™öÃÿâ∫¡¶°¢≈≈ÀÆπÐ∫ÕÎp√Ð∑‚πе¿œµΩy(t®Øng)£¨Ω‚õQΩåŸ∫Õ∆‰À˚¥ŒÉû(y®≠u)≤ƒ¡œéßÅ̵ƒ÷T∂ýÃÙë(zh®§n)°£
More Information |
|
 |
Life Sciences
…˙√¸ø∆åW
…˙√¸ø∆åW –àˆ÷–åçÚû “‘O ©µƒ“™«Û“™«Û≤ªÉH“™Ã·π©ùM◊„‘O ©»ÀÜT÷∏ƒœ∫Õ∆⁄Õ˚µƒ∏þŸ|¡øπ§ÀáÀÆ£®RO/DI£©πе¿œµΩy(t®Øng)£¨∂¯«““™Ã·π©þmÆî/∞≤»´µƒþ\ðî∫ÕÃé¿ÌåçÚû “≈≈∑≈µƒÃÿ ‚èUŒÔ°£“Ú¥À£¨Ö¢≈cþ@–©‘O ©‘O”ã∫Õþ\––µƒ»ÀÜT–Ë“™Ã·π©þ@–©πе¿œµΩy(t®Øng)µƒ÷∆‘υõƒ÷∏åß∫Õºº–gå£òI(y®®)÷™◊R°£°£
More Information
|
Marine∫£—Û
‘⁄∫£—Ûë™”√÷–∑¿÷π∏ØŒg±»∆‰À˚»Œ∫Œµÿ∑Ω∂º÷ÿ“™°£å¶”⁄GFπе¿œµΩy(t®Øng)£¨∏ØŒg≤ª‘Ÿ «ÜñÓ}°£–‘Ér±»∏þ£¨Ÿ|¡ø∫√£¨ÀСœ «ƒ˙µƒ’˝¥_þxìÒ°£GFå¢éÕ÷˙ƒ˙Õ®þ^úp…ŸæS◊oïrÈg∫ÕøÇÛwþ\ÝI≥…±æÅÌ÷∏þÆa¡ø°£ÔL°¢”Í∫ÕœÃÀÆå¶Ω®÷˛ŒÔ°¢∑øŒð∫Õπ©ÀÆπÐæĵƒ”∞Ìë∑«≥£¥Û°£¿‰ü·ÀÆ°¢Œ€ÀÆ∫Õª“ÀÆ°¢”ÍÀƺØÀÆ∫ÕªØåW∆∑∑÷≈‰µƒπе¿‘⁄É»≤ø∫ÕÕ‚≤ø еΩ∏ØŒg∫ÕÀÆπ∏µƒ”∞Ìë”»ûÈá¿÷ÿ°£ÅÌ◊‘GFπе¿œµΩy(t®Øng)µƒΩ‚õQ∑Ω∞∏±£◊CÔã”√ÀÆ∫Õ∆‰À˚π§ÀᡘÛwµƒ∞≤»´ðîÀÕ£¨∂¯≤ªï˛∏ƒ◊ÉÀ¸ÇɵƒŸ|¡ø°£
More Information |
 |
 |
Micro Electronics∞ÎåßÛw
Œ¢Îä◊” –àˆ£®∞ÎåßÛw£©¿^¿m(x®¥)◊Ò—≠ƒ¶Ýñ∂®¬…£¨åß÷¬À˘”–π§ÀᡘÛwæþ”–∏¸á¿∏Òµƒ“é(gu®©)∏Ò£¨–Ë“™∏¸«Âù絃≤ƒ¡œÅÌÃé¿Ì∫ÕðîÀÕþ@–©¡˜Ûw°£≈c¥ÀÕ¨ïr£¨þ@–©π§èSµƒ“é(gu®©)ƒ£’˝‘⁄îU¥Û£¨þ@“‚Œ∂÷¯∏¸¥ÛµƒœµΩy(t®Øng)°£æßàAèSµƒ≠h(hu®¢n)æ≥ólº˛“≤‘ΩÅÌ‘Ωá¿∏Ò£¨“™«Û∏¸∂ýµƒPCW≈c∏¸√Ы–µƒπ´≤Ó°£GF胒˚ÇÄπ§èSµƒœµΩy(t®Øng)Ω«∂»≥ˆ∞l(f®°)£¨Õ®þ^’˝¥_µƒ≤ƒ¡œþxìÒ∫ÕèV∑∫ π”√ü·ÀЖ‘ÀСœµƒºº–g÷ß≥÷£¨¥_∂®¡ÀŒ“Çɵƒ‘ˆ÷µ¸c°£
More Information |
Water and GasÀÆ∫ÕÃÏ»ªö‚
ÀÆ∫ÕÃÏ»ªö‚‘O ©÷–≈‰ÎäæĬ∑∫ÕþBΩ”µƒ∞≤»´–‘∫Õø…øø–‘ «∏þ–‘ƒÐπ©ë™œµΩy(t®Øng)≤ªø…ªÚ»±µƒª˘µA°£Œ“ÇÉÕ®þ^∏…æÄ°¢≈‰ÎäæÄ∫Õ∑˛Ñ’æĵƒ≤ƒ¡œ™ö¡¢þBΩ”ÅÌùM◊„∞≤»´–‘∫Õø…øø–‘µƒ“™«Û°£GFÆa∆∑∫ÕΩ‚õQ∑Ω∞∏∫≠…w¡À胑¥Ó^µΩ π”√¸cµƒÀ˘”–åç”√≥Öڰ£πе¿°¢πк˛°¢ÈyÈTµ»≤øº˛µƒþBΩ”±ÿÌö∞≤»´ø…øø°£üo’ì «‘⁄ÀƪÚö‚Ûw∑÷≤º÷–£¨”√”⁄∏…æÄ°¢∑˛Ñ’æĪڜ˚∑¿À®°£“ªÇÄ∞≤»´µƒþBΩ”°™°™ÃÿÑe «≤ªÕ¨≤ƒ¡œµƒþBΩ”°™°™ ºΩK « ◊“™ÍP◊¢µƒÜñÓ}°£º¥ π嶔⁄¿ßÎyµƒþBΩ”£¨GFπе¿œµΩy(t®Øng)“≤”–’˝¥_µƒΩ‚õQ∑Ω∞∏°£
Market Segments |
 |
|
Water and Waste Water Treatment
èUÀÆÃé¿Ì∫ÕÀƪÿ ’
ÍPÊIµƒ∞l(f®°)’𣨻ÁèUÀÆÃé¿Ì∫ÕÀƪÿ ’µƒ”–·ò嶖‘µƒΩY∫œ£¨“‘º∞èUŒÔÞDªØûȃБ¥µƒþ^≥㨖˓™Éû(y®≠u)ªØŸ|¡ø°¢≥…±æ–ß“Ê∫Õ≠h(hu®¢n)æ≥“ÚÀÿ°£GFπе¿œµΩy(t®Øng)µƒœ»þMÀСœΩ‚õQ∑Ω∞∏ºØ≥…‘⁄∏˜∑Në™”√÷–£¨º”èä¡ÀÀÆ∫ÕèUÀÆÃé¿Ìë(zh®§n)¬‘µƒø…≥÷¿m(x®¥)–‘°£üo’ìƒ˙å¶Ôã”√ÀÆ°¢≥« –èUÀÆ°¢π§òI(y®®)þ^≥êÚèUÀÆÃé¿Ì”–∫Œ≈d»§°≠°≠Œ“ÇÉ∂ºø…“‘¿˚”√20∂ý∑N≤ªÕ¨≤ƒ¡œµƒ™öÃÿâ∫¡¶°¢≈≈ÀÆπÐ∫ÕÎp√Ð∑‚πе¿œµΩy(t®Øng)£¨Ω‚õQΩåŸ∫Õ∆‰À˚¥ŒÉû(y®≠u)≤ƒ¡œéßÅ̵ƒ÷T∂ýÃÙë(zh®§n)°£
Market Segments |
|
Market Segments
Cooling / F & B
Cooling
It is the expressed intention of GF Piping Systems to be part of this world-wide initiative to optimize refrigeration and cooling plants in terms of energy use and environmental impact. How efficiently an entire refrigeration plant operates is defined by the machinery°Øs COP (Coefficient of Performance), the efficiency of the secondary piping system and the heat transfer rate at the air cooler. Thus, the secondary piping system plays a vital role in the efficiency of the plant as a whole. GF°Øs COOL-FIT is a pre-insulated complete plastic piping system, designed specifically to optimize the efficiency, installation costs and life span of the secondary piping system.
More Information
Chemical Processing
CPI
GF Piping Systems operates behind the scenes in a multitude of chemical processes. The harsh environment in chemical plants and chemical conveyance, places high demands on piping systems in regard to safety, efficiency and maintenance. Thanks to our decades-long experience and our extensive know-how, we are able to ensure the highest degree of quality and safety for our products as well as for the people in the surrounding area. For over 50 years, industry has trusted thermoplastic pressure piping systems from GF Piping Systems for any number of industrial applications from water for process cooling to transporting hazardous liquids. Our proven plastic piping systems offer a maximum of corrosion protection, even in challenging industrial sectors such as the chemical industry.
More Information
Data Center
Data_Center_Teaser
As Data Centers are working to be more efficient users of energy, they're turning towards highly efficient liquid cooling to improve the effectiveness of systems. GF Piping Systems provides leading edge piping systems for mission critical cooling required by the new demands for efficient Data Center cooling. GF Piping Systems offers maintenance free plastic solutions, offsite modular fabrication to enable faster build-outs, fast installation with no hot works required, up to 70% weight reduction, higher efficiency piping systems, significant cost savings in labor, and engineering services that include system review, skid and modular design.
More Information
Energy
Energy
In the growing sense of sustainability profound changes are beginning to transform the way energy is produced, delivered and used. We at GF Piping Systems provide intelligent plastic solutions for successfully managing the highly specialized water and chemical applications in today's and tomorrow's energy production.
Whether your interest is in conventional power plants, renewable energies, or pioneering green solutions°≠ we can address many of the challenges posed by metals and other sub-optimal materials with over 20 unique pressure, drain and double containment piping systems in several different materials.
More Information
Life_Sciences
Requirements of laboratory facilities within the Life Science market call for a need to not only provide high quality process water (RO/DI) piping systems that meet the guidelines and expectations of facility personnel, but to also provide proper/safe conveyance and treatment of discharged special waste from the laboratories. Therefore those involved in the design and operation of these facilities require guidance and technical expertise from manufacturers providing these piping systems.
More Information
Marine
Ship_building_retouchiert
Preventing corrosion in Marine applications is more important here than anywhere else. With GF Piping Systems, corrosion is no longer an issue. Cost-effective and high-quality, plastics are your right choice. GF will help you increase production by reducing maintenance time and overall operational cost. Wind, rain and saltwater can be very harsh on structures, housing and supply lines. The pipelines for hot and cold water, effluent and greywater, rain catchment and chemical distribution are particularly affected, internally and externally, by corrosion as well as incrustation. The solutions from GF Piping Systems warrant the safe conveyance of drinking water and other process fluids ®C without altering their quality in the least.
More Information
Micro Electronics
Microelectronics
The Micro-Electronics Market (semi-conductor) continues to follow Moore°Øs Law resulting in all process fluids having tougher specifications, requiring ever cleaner materials to process and convey these fluids. At the same time these factories are increasing in size meaning larger systems. Fab environmental conditions are also getting tighter requiring more PCW with closer tolerances. GF takes a systems view of the entire factory and has determined where we add the most value by proper material selection and technical support for using our wide range of Thermal Plastics.
More Information
Water and Gas
Water_Gas
Security and reliability of distribution lines and connections in water and gas utilities is an indispensable basis for high performing supply systems. We meet this demand for safety and reliability with material-independent connections for main lines, distribution lines and service lines. GF products and solutions cover all utility applications from the source to the point of use.
Pipes, fittings, valves and other components need to be connected safely and reliably. Whether in water or gas distribution, for main lines, service lines or hydrants. A safe connection ®C especially with differing materials ®C is always a primary concern. GF Piping Systems has the right solution even for your most difficult connections.
More Information
Water and Waste Water Treatment
Water_Treatment
Key developments such as the targeted combination of waste water treatment and water recovery, as well as waste to energy processes, require optimization of quality, cost-efficiency and environmental factors. Integrated in various applications, advanced plastic solutions from GF Piping Systems strengthen the sustainability of water and waste water treatment strategies.
Whether your interest is in drinking water, municipal waste water, industrial process or waste water treatment°≠ we can address many of the challenges posed by metals and other sub-optimal materials with over 20 unique pressure, drain and double containment piping systems in several different materials.
More Information
|

